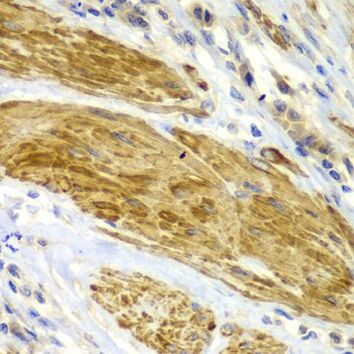
CDK6 Antibody in Immunohistochemistry (Paraffin) (IHC (P))

Search
Invitrogen
CDK6 Polyclonal Antibody
{{$productOrderCtrl.translations['antibody.pdp.commerceCard.promotion.promotions']}}
{{$productOrderCtrl.translations['antibody.pdp.commerceCard.promotion.viewpromo']}}
{{$productOrderCtrl.translations['antibody.pdp.commerceCard.promotion.promocode']}}: {{promo.promoCode}} {{promo.promoTitle}} {{promo.promoDescription}}. {{$productOrderCtrl.translations['antibody.pdp.commerceCard.promotion.learnmore']}}
产品信息
PA5-87490
宿主/亚型
分类
类型
抗原
偶联物
形式
浓度
规格
保存条件
运输条件
RRID
产品详细信息
Positive Samples: Jurkat, Mouse liver, Rat brain; Cellular Location: Cell projection, Cytoplasm, Nucleus, centrosome, cytoskeleton, microtubule organizing center, ruffle
靶标信息
CDK6 functions as a cell-cycle initiator protein. This protein is coexpressed and copurified with CyclinD1. They are critical regulators of cell cycle progression. The prototype member of this family, p34cdc2, and a related protein cdk2, function late in the cycle while cdk4 and cdk6 are critically involved in G1 to S progression. CDK6 is essential for cell proliferation within the dentate gyrus of the hippocampus and the cuventricular zone of the lateral ventricles. Mutations in the gene results in microcephaly 12, primary, autosomal recessive (MCPH12).
仅用于科研。不用于诊断过程。未经明确授权不得转售。